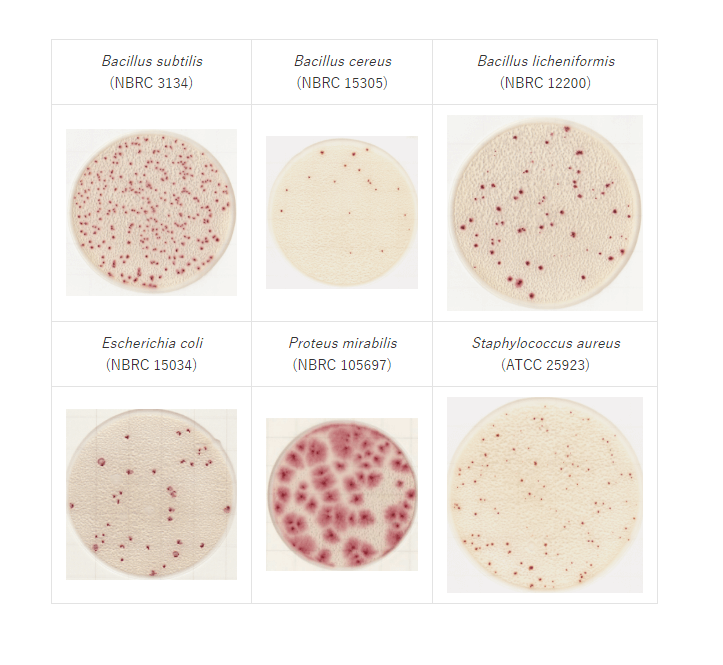

Easy Plate AC for måling av aerobe bakterier, 100 stk
kr 1 611,25 (ink. mva)
Klargjort dyrkningsplate for påvisning av totalantall bakterier.
Beskrivelse
Easy Plate AC Totalkim for måling av totalantall aerobe bakterier
Easy Plate AC er et mikrobiologisk kultiveringssystem for påvisning av totalantall bakterier bestående av en vanntett plate med klargjort tørket dyrkningsmedia og en transparent folie over. Easy Plate AC er kompakt og enkel i bruk for å påvise totalantall bakterier. Dyrkningsmediet i platene er optimalisert for påvisning av totalantall bakterier som lever under aerobe forhold, dvs. at de har tilgang på oksygen.
Platene muliggjør raskere og enklere mikrobiologiske bakterietest av matvarer og hjelper dermed til med en høyere matsikkerhet. Platene kan benyttes for å teste antall bakterier i råvarer, så vel som ferdige produkter som mat drikke, kjøtt, kosmetikk eller andre prøver.
Det er også mulig å bruke platene for å ta prøver av overflater ved å trykke de mot ønsket overflate.
Fremgangsmåte for prøvemåling:
- Legg platen på et flatt underlag, og vent til platen har nådd romtemperatur.
- Løft opp plastfilmen og påfør 1 mL fortynnet prøve i platens senter.
- Legg plastfilmen tilbake over platen og la platen ligge rolig til prøven ha diffundert over hele platen. Minimum 3 minutter.
- Plasser platen i inkubator. Opptil 25 plater kan stables under inkubering.
Fremgangsmåte for overflatemåling:
- Legg platen på et flatt underlag, og vent til platen har nådd romtemperatur.
- Løft opp plastfilmen og påfør 1 mL NaCl løsning i platens senter.
- La platen ligge rolig til prøven ha diffundert over hele platen og dyrkningsmediet har absorbert væsken. Minimum 15 minutter.
- Press platen mot ønsket overflate. Viktig at det ikke presses for hardt.
- Legg plastfilmen tilbake over platen og plasser platen i inkubator.
- Dyrkningsmediets overflate er ca. 20 cm².
Easy Plate AC bakterietester har følgende fordeler:
- Ingen forarbeider med dyrkningsmedia.
- Raskere prøvepåføring uten spesialutstyr.
- Enkel i bruk, krever ikke omfattende opplæring.
- Testresultatene har høy korrelasjon med tradisjonelle påvisningsmetoder.
- Plassbesparende, da opptil 25 plater kan stables under inkubasjon.
Spesifikasjoner:
| Inkuberingstid: | 48 ± 2 timer ved 35 ± 1 °C |
| Kolonifarge: | Rød |
| Oppbevaring: | Lagres ved 2 til 8 °C |
Tilleggsinformasjon
| Vekt | 1 kg |
|---|---|
| Produsent |
Tilbehør
Brosjyre
manual
video
Video viser bruk av Easy Plate